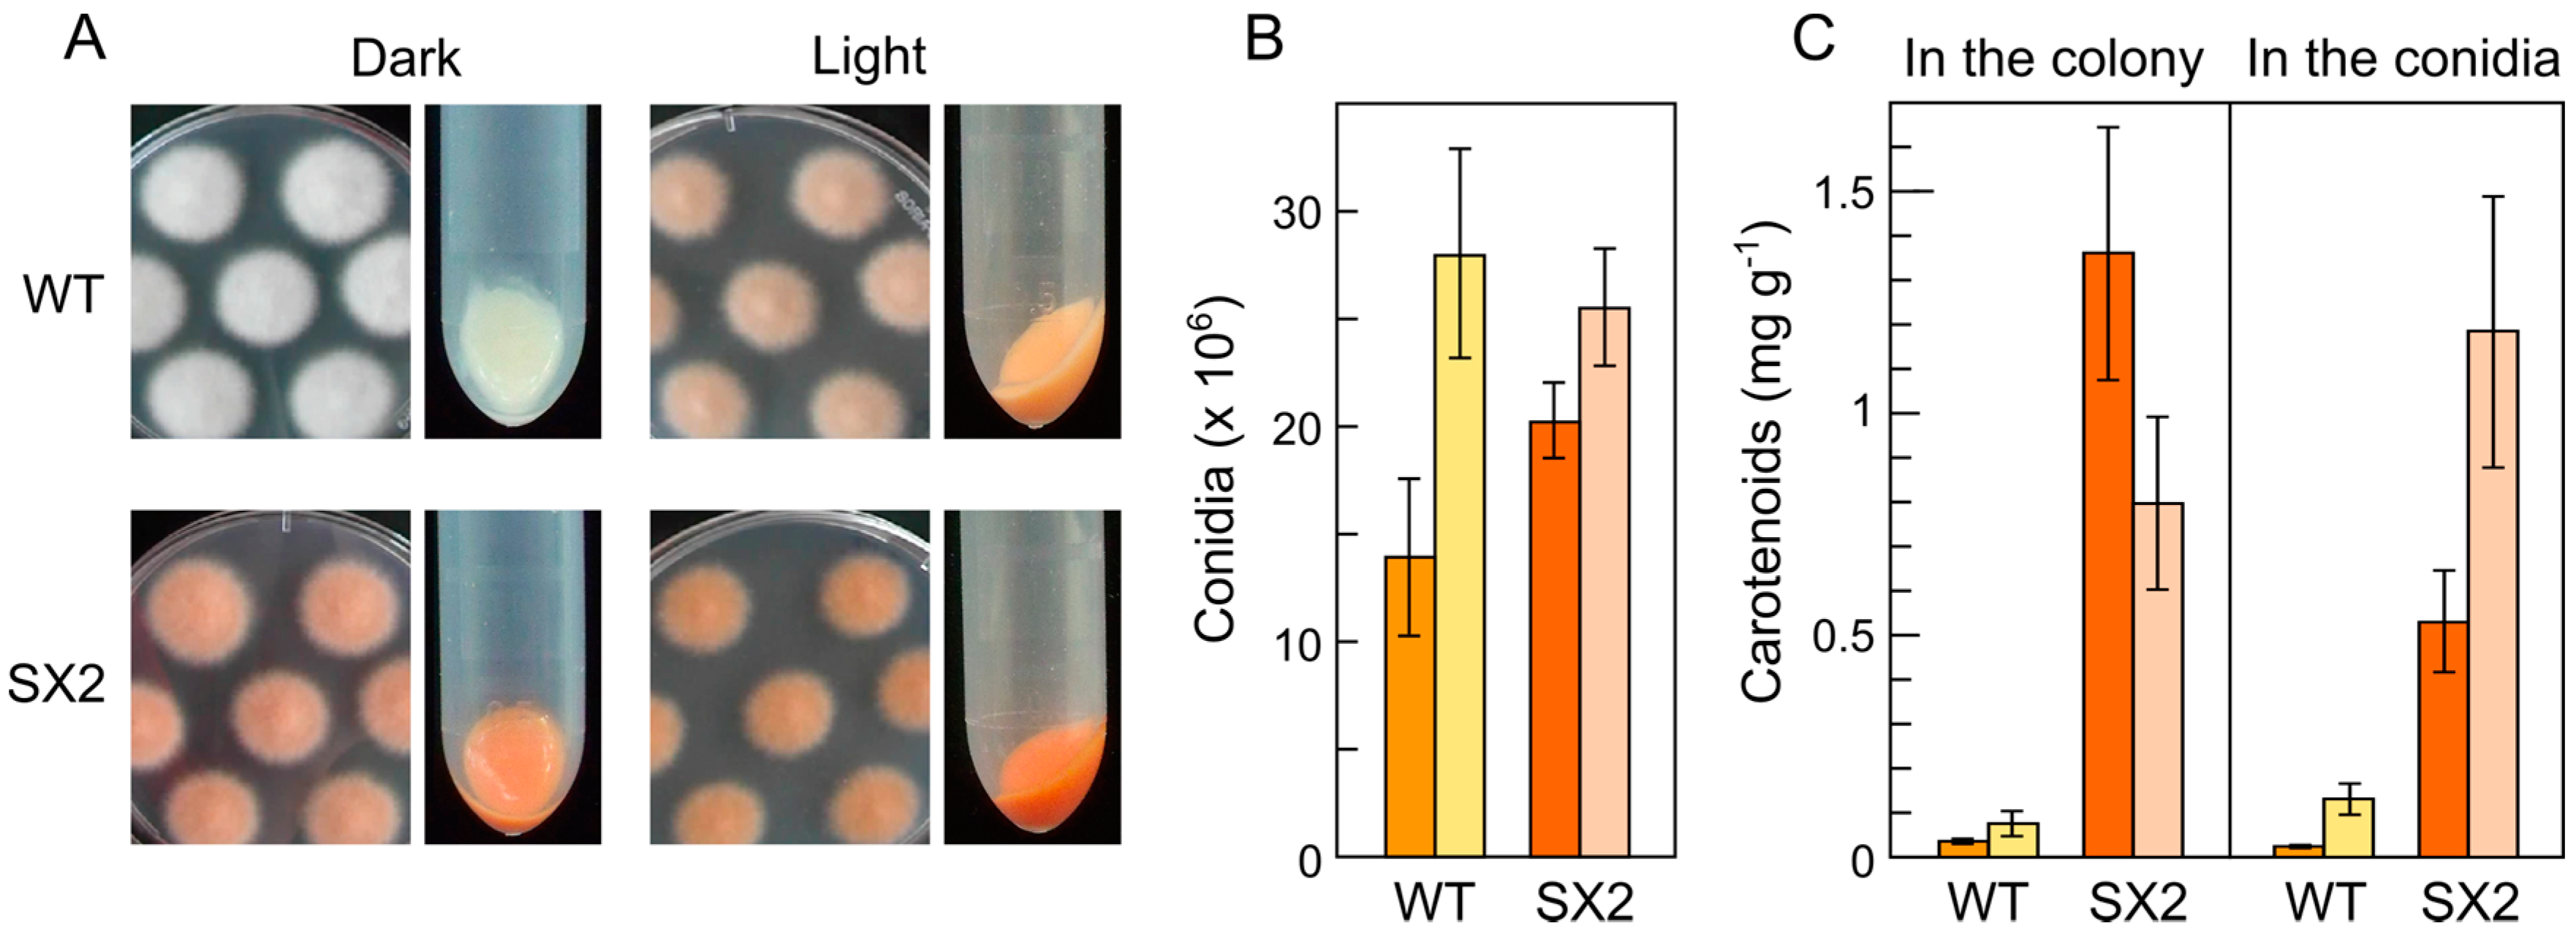
Jof 03 00039 g005

Abstract
Many fungi of the genus Fusarium stand out for the complexity of their secondary metabolism. Individual species may differ in their metabolic capacities, but they usually share the ability to synthesize carotenoids, a family of hydrophobic terpenoid pigments widely distributed in nature. Early studies on carotenoid biosynthesis in Fusarium aquaeductuum have been recently extended in Fusarium fujikuroi and Fusarium oxysporum, well-known biotechnological and phytopathogenic models, respectively. The major Fusarium carotenoid is neurosporaxanthin, a carboxylic xanthophyll synthesized from geranylgeranyl pyrophosphate through the activity of four enzymes, encoded by the genes carRA, carB, carT and carD. These fungi produce also minor amounts of β-carotene, which may be cleaved by the CarX oxygenase to produce retinal, the rhodopsin’s chromophore. The genes needed to produce retinal are organized in a gene cluster with a rhodopsin gene, while other carotenoid genes are not linked. In the investigated Fusarium species, the synthesis of carotenoids is induced by light through the transcriptional induction of the structural genes. In some species, deep-pigmented mutants with up-regulated expression of these genes are affected in the regulatory gene carS. The molecular mechanisms underlying the control by light and by the CarS protein are currently under investigation.
1. Introduction
The genus Fusarium is a complex group of phytopathogenic fungi, consisting of more than one thousand species [1], many of which have been the object of detailed attention [2]. Different Fusarium species were found to produce a large array of secondary metabolites. Some of them are pigments, and color variations have been used from long ago as distinctive traits of different strains (see, e.g., [3]). A most characteristic class of fungal pigments are the carotenoids, a family of lipophilic terpenoids ubiquitous in all major taxonomic groups [4,5]. The carotenoids are synthesized by all photosynthetic organisms, from cyanobacteria to higher plants, but they are also produced by diverse heterotrophic microorganisms, including fungi [6,7] and non-photosynthetic bacteria [8,9]. There are more than 750 natural carotenoids [5], providing typical yellowish, orange or reddish pigmentations to many plant organs, microorganisms and animals. With some notable exceptions in aphids [10], the animals are generally unable to synthesize carotenoids, and they get them through the diet. Carotenoids are especially relevant in photosynthetic species, where they play essential roles in light harvesting and photoprotection of the photosynthetic machinery [11] and in animals as a source for retinoids, i.e., retinal and retinoic acid [12]. However, the carotenoids do not seem to play essential roles in fungi, where their absence has no apparent phenotypic consequences apart of altered pigmentation [13].
As terpenoids, the synthesis of carotenoids derives from the condensation of C5 isoprene units [4,5]. The universal terpenoid precursor is isopentenyl pyrophosphate (IPP), which can be synthesized either from mevalonate, produced from hydroxymethylglutaryl coenzyme A (HMG-CoA) (mevalonate pathway), or from derivatives of d-1-deoxyxylulose 1-phosphate, generated from the condensation of pyruvate and glyceraldehyde 3-phosphate (non-mevalonate pathway, [14]). In the cases investigated, fungal IPP is produced through the mevalonate pathway, while for carotenoids in bacteria and photosynthetic species IPP is produced through the non-mevalonate pathway, localized in plastids in the eukaryotic organisms. The early biosynthetic steps involve the sequential additions of IPP (isoprene, C5) units to produce geranyl pyrophosphate (GPP, C10), farnesyl pyrophosphate (FPP, C15), and geranylgeranyl pyrophosphate (GGPP, C20), carried out by prenyl transferases [4,5]. The first molecule with the characteristic aliphatic carotenoid-like structure is the colorless 15-cis-phytoene, consisting of a symmetrical polyene chain formed by the condensation of two GGPP units by phytoene synthase (Figure 1). The light-absorbing features of colored carotenoids are due to the presence of a chromophore, consisting of a series of conjugated double bonds generated by the activity of desaturase enzymes. Different subsequent chemical changes, usually the introduction of a cyclic end group (β and ε rings are the most common, while γ, κ, φ and χ rings are less frequent) on at least one of the ends of the molecule, and/or oxidative reactions (e.g., hydroxylation, epoxidation, carboxylation, esterification, etc), gives rise to the large diversity of known carotenoids [5].
Figure 1.
Carotenoid biosynthesis in Fusarium. Gene products responsible for the biosynthetic steps are indicated close to each arrow. Genomic organization of the genes is shown in the inserted box. Carotenoids detected in the High Performance Liquid Chromatography (HPLC) analyses described in Figure 4 are shaded in orange. Compounds shaded in blue (dotted box) are not detected in the chromatograms because of lack of absorption in the covered detection range (350–600 nm).
2. Fusarium Carotenoids
Early reports mentioned the occurrence of carotenoids in Fusarium species, e.g., F. oxysporum [3], but the first detailed biochemical analyses were described in Fusarium aquaeductuum [15]. Such analyses showed the occurrence of non-polar carotenoids and an acidic carotenoid fraction, which reminded the one assigned as the xanthophyll neurosporaxanthin (hereafter NX) in Neurospora crassa [16]. NX is a carboxylic C35 apocarotenoid, chemically defined as β-apo-4′-carotenoic acid [17]. NX is not a frequent carotenoid in fungi, and to date, besides the genera Neurospora and Fusarium, it has been only found in Verticillium [18,19] and Podospora [20].
Carotenoid analyses were refined in F. aquaeductuum in subsequent years, and confirmed the occurrence of NX together with precursor neutral carotenes, that included ζ-carotene, neurosporene, lycopene, γ-carotene, and torulene [21]. Later studies in Fusarium fujikuroi, and data presented in Section 5, corroborated the carotenoid composition of F. aquaeductuum with the exception of the detection of β-zeacarotene instead of lycopene. This indicates that the cyclization may be achieved either on neurosporene or on lycopene, depending on the species. Taken together, the chemical analyses are consistent with the biosynthetic pathway depicted in Figure 1. From phytoene, five desaturations and the cyclization of the non-saturated end yield the reddish torulene. The steps from torulene to NX were deduced from the enzymatic activities of the responsible enzymes, discussed below. In F. fujikuroi there are minor amounts of β-carotene [22], showing that the CarRA cyclase is also able to recognize γ-carotene as substrate. Because of its carboxylic group, NX may be a subject of esterification. In a marine Fusarium species, a fraction of the produced NX is accumulated as a glycosyl ester [23].
3. Genes and Enzymes of Carotenoid Metabolism in Fusarium
Some of the enzymes responsible for early steps of the terpenoid pathway were first identified in F. fujikuroi thanks to the similarity with formerly known enzymes. The typical cloning protocol consisted in the identification of conserved protein segments, the design of degenerate primers from such sequences to clone the corresponding internal gene segment by PCR, and the use of the amplified segment as a probe to clone the whole gene through the screening of a genomic library. Such methodology led to clone the genes for HMG-CoA reductase [24], producing mevalonate, and the prenyl transferases responsible for the synthesis of FPP [25] and its conversion to GGPP [26]. The mutants of these genes are expected to be non-viable because of their participation in the synthesis of essential terpenoids, and therefore their functions were inferred from their close relatedness with orthologs in other organisms. F. fujikuroi contains a second GGPP synthase located in the cluster for the synthesis of gibberellins, growth-inducing plant hormones of the terpenoid family. This second GGPP synthase gene is presumably specific for the synthesis of these secondary metabolites, as it indicates its coregulation with most of the genes from the gibberellin cluster [27].
The first gene specifically involved in the synthesis of carotenoids known in Fusarium was carB [28], identified by a PCR strategy similar to the one mentioned above through its sequence similarity to the N. crassa ortholog al-1 [29]. The function of the gene was confirmed by complementation of a phytoene-accumulating albino mutant and by generation of the same phenotype by carB targeted mutation. The CarB enzyme is responsible for the five desaturation steps of the NX biosynthetic pathway, as it indicated the identification of a carB mutant allele specifically affected in the fifth desaturation [30]. This was in accordance with former observations with al-1 of N. crassa: its expression in Escherichia coli or in vitro studies with purified AL-1 enzyme demonstrated its capacity to carry out the five desaturation steps for NX biosynthesis in this species [31]. Closely linked to carB it was found the gene carRA (Figure 1), orthologous of phytoene synthase al-2 of N. crassa [32] and interpreted as the phytoene synthase of Fusarium, a conclusion consistent with the albino phenotype of their mutants [33]. In both species, a carboxylic domain with similarity to carotene cyclases precedes the phytoene synthase domain. The cyclase domain has a high conservation with that of the orthologous gene crtYB of the yeast Xanthophyllomyces dendrorhous, where the cyclase activity was biochemically demonstrated [34]. No mutants specifically affected in the cyclase activity have been described in Fusarium, but the mutants of the cyclase domain of the al-2 gene of N. crassa were shown to be defective in the cyclization step [35,36]. Taken together, the available data strongly suggest the same function for the amino domain of the CarRA protein of F. fujikuroi.
The reactions from torulene to NX include a carotenoid cleavage step, typically achieved by a family of enzymes known as carotenoid oxygenases [37]. A gene for an enzyme of this family, called carX, was found to be linked and transcribed divergently from the gene carRA (Figure 1). However, its targeted mutation did not impede the synthesis of NX [38], and the study of its enzymatic activity revealed that it cleaved β-carotene symmetrically to produce retinal [39]. Interestingly, the carX/carRA/carB cluster is linked to a rhodopsin gene, called carO because of its regulatory connections with the rest of the genes of the cluster (see next sections). The rhodopsins typically bind retinal as a light-absorbing prosthetic group, providing coherence to the gene organization of the cluster: the genes carRA, carB, and carX are necessary to produce retinal, which is presumably used by the rhodopsin encoded by the coregulated carO gene. Retinal might be also used for a second rhodopsin, encoded by the gene opsA [40]. In addition, retinal might be subject to further chemical reactions. The Fusarium genomes contain a gene for an aldehyde dehydrogenase highly similar to RALDH enzymes converting retinal to retinoic acid in mammals. This enzyme, that was called CarY, was investigated in F. verticillioides and found to exhibit such enzymatic activity in vitro [41]. Targeted mutation of the carY gene in F. verticillioides had no effect on carotenogenesis, but resulted in diverse developmental alterations. However, no retinoic acid could be detected in the control fungal cells and hence the biochemical function of the CarY enzyme in Fusarium has not been solidly established.
The Fusarium genes responsible for the conversion of torulene to NX have been recently described. The search for genes encoding other putative carotenoid oxygenases in the Fusarium genome databases led to identify the gene carT, whose function was revealed by the presence of a mutation in a torulene accumulating mutant and its genetic complementation with the wild-type carT allele [42]. As biochemical confirmation, purified CarT enzyme efficiently cleaved torulene in vitro to produce β-apo-4′-carotenal. As additional support, the targeted mutation of its ortholog in N. crassa, called cao-2 from carotenoid oxygenase, resulted in the block of NX production and the accumulation of torulene [43]. These findings established a new enzymatic class in the carotenoid oxygenase family. The function of the gene carT in Fusarium carotenogenesis, together with those of the genes carRA and carB, was also confirmed by targeted gene disruption in Gibberella zeae, teleomorph of Fusarium graminearum [44].
The product of CarT, β-apo-4′-carotenal, requires a further oxidation to produce NX. The responsible gene was first discovered in N. crassa thanks to the study of a yellow mutant, called ylo-1. This mutant exhibited a puzzling biochemical phenotype, since it contained a complex carotenoid mixture that varied with the culture conditions and that did not include NX [45,46]. The gene ylo-1 encodes an aldehyde dehydrogenase mediating the last step of NX biosynthesis, as demonstrated in its ability to complement the ylo-1 mutation [47] and the capacity of purified YLO-1 protein to convert in vitro β-apo-4′-carotenal into NX. This finding allowed the identification of the orthologous gene in F. fujikuroi, that was called carD [48]. The function of carD was confirmed by targeted mutation, which resulted in the lack of NX and the accumulation of unusual carotenoids, interpreted as β-apo-4′-carotenal derivatives.
4. Regulation by Light
Early observations in F. oxysporum revealed that illumination promotes the accumulation of carotenoids in the mycelium [3]. First detailed studies on the effect of light were carried out with F. aquaeductuum. In an initial report, focused on the effect of temperature on the photoinduction process [49], the time course of the response to a transient light exposure revealed a gradual carotenoid accumulation that reached a maximum at about 12 h after illumination. However, the synthesis keeps increasing at a slower rate for at least three days if the culture is maintained under light [50]. Regarding the effect of temperature, the secondary reaction (formation of colored carotenoids) decreases at lower temperatures while the primary reaction to light, presumably a photochemical process, is independent of temperature in the range of 5–25 °C.
The photoinduction is ineffective under anaerobic conditions, as indicated by the lack of carotenoid accumulation if the illuminated mycelia are transferred to an oxygen-free atmosphere [51]. However, the photoinduced state is maintained, as indicated by the onset of carotenoid biosynthesis if the aerobic conditions are restored, even in the dark. Under aeration, the photoinduction requires protein synthesis, as shown by the lack of response if cycloheximide is added before or immediately after light exposure [50]. As happens with anaerobiosis, the removal of cycloheximide allows the start of carotenoid accumulation at any time in the dark, at least up to 30 h, pointing again to a high stability of the induced state of the photoreception system. In an ingenious experiment, when a F. aquaeductuum culture was illuminated, incubated in the dark to allow the start of enzyme production, and then exposed to anaerobiosis and to cycloheximide to block further enzyme production, there was no carotenoid production. However, if the culture was returned afterwards to aerobiosis, carotenoid biosynthesis started even in the presence of cycloheximide, indicating that the effect of anaerobiosis is at the level of enzyme activity, and that the enzymes are sufficiently stable [51].
In F. aquaeductuum, the effect of light may be partially replaced by the addition of the sulfhydryl oxidizing reagents p-chloro- and p-hydroxymercuribenzoate [50,52] or the oxidative reagent hydrogen peroxide [53], suggesting that oxidation of -SH groups plays a role in the light detection system. Accordingly, the photoinduction is abolished upon addition of reducing agents as dithionite and hydroxylamine, but the response is recuperated if the reducing agent is removed, indicating the recovery of the photoreceptor system [53]. However, while a short exposure to light is sufficient for a sustained photoinduction, p-hydroxymercuribenzoate must be all the time present to maintain its stimulating effect, and such stimulation is additive with that of light [54], indicating different mechanisms of action. Moreover, p-hydroxymercuribenzoate was ineffective in F. fujikuroi in the dark, while this species exhibits a similar photoinduction [55].
The study of light dependence of the photoinduction in F. aquaeductuum [56] showed that the amount of produced carotenoids depends on the incident light over a 100-fold range, with a reciprocity law holding true over a wide range of exposure times and light intensities. Action spectrum for NX photoinduction extends from 400 to 500 nm, with maxima at 375/380 nm and 450/455 nm and a shoulder at 430/440 nm, a shape consistent with the participation of a flavin photoreceptor. No induction is detected with wavelengths beyond 500 nm, and actually red light proved to be ineffective, discarding the participation of a phytochrome-like photoreceptor [57]. However, incubation of the fungus with methylene blue or toluidine blue allows it to respond to red light [58], suggesting that these chemicals may act as artificial photoreceptors. The shape of the action spectrum also discards the carotenoids as light-absorbing chromophores. As supporting evidence, the accumulation of phytoene in the albino carB mutant SG43 is still dependent on light [22], and the mutants of gene carX [38], involved in retinal formation, or those of the rhodopsin genes carO [59] and opsA [40] exhibit a full carotenoid photoinduction.
In N. crassa, a fungus with a similar action spectrum for light-induced carotenoid biosynthesis [60], the photoinduction is totally dependent on the White Collar complex, consisting of the photoreceptor WC-1 and its partner WC-2 (reviewed by [61]). However, the mutants of the wc-1 orthologous genes of F. fujikuroi (wcoA [62]) and F. oxysporum (wc1 [63]) conserve to different extents a detectable carotenoid photoinduction under continuous illumination. The targeted mutation of the orthologous wc-1 and wc-2 genes in F. graminearum, fgwc-1 and fgwc-2, result in a paler pigmentation of the surface colonies under light, but the levels of carotenoids either in the wild type and the mutants were not chemically determined [64].
The analysis of carotenoid accumulation on surface cultures revealed a two-stage response in F. fujikuroi, with a first rapid increase dependent on WcoA and a slower subsequent carotenoid accumulation depending on another flavin photoreceptor, the DASH cryptochrome CryD [65]. The photoactivity of this flavin photoreceptor has been experimentally demonstrated [66], and its participation as a second photoreceptor explains the maintenance of photoinduced carotenoid accumulation in the wcoA mutants under constant illumination. The photoreceptors WcoA and CryD are not only involved in the regulation of carotenogenesis, as indicated by the alteration in the production of other pigments and secondary metabolites in their corresponding mutants [62,67], even in the dark in the case of WcoA.
The photoinduction of Fusarium carotenogenesis results from a rapid increase in the transcript levels of most of the structural genes. Northern blot experiments in F. fujikuroi showed similar induction kinetics for the four genes of the car cluster, carRA, carB, carO [59], and carX [38], as well as carT [42]. The transcripts reach maximal levels after one hour of exposure to light and decay afterwards, a down-regulating phenomenon known as photoadaptation. This photoinduction pattern has been confirmed by RT-qPCR approaches (Figure 2), and similar results have been obtained in F. oxysporum [68] and F. verticillioides [69]. The transcriptional photoresponse is similar to the one exhibited by the orthologous genes in N. crassa (reviewed by [70]), with the exception of the GGPP synthase gene al-3, that exhibits in this fungus a strong photoinduction while its F. fujikuroi ortholog ggs1 is hardly affected by light [26]. Our recent RNA-seq data have revealed however a significant photoinduction of ggs1 mRNA (Figure 3). A minor photoresponse was exhibited by the gene carD from F. fujikuroi [47], corroborated by the RNA-seq data (Figure 3), while no photoinduction was detected in the case of ylo-1 from N. crassa [48], both genes encoding the ALDH enzymes responsible for the last reaction for NX production (Section 3). Therefore, in F. fujikuroi, the whole NX biosynthetic pathway is regulated by light.
Figure 2.
Photoinduction of carotenogenesis in F. fujikuroi. (A) Aspect of 7-day old colonies of the wild type IMI58289 grown on minimal medium in the dark or under continuous illumination; (B) Example of the kinetics of mRNA accumulation for the genes carRA, carB, and carT in the wild type FKMC1995. Transcript levels were determined by RT-qPCR (real time quantitative PCR) and referred to those of β-tubulin gene. Levels in the dark for each gene were taken as 1 (adapted from [65]).

Figure 3.
Effect of light and carS mutation on the expression levels for the Fusarium genes involved in carotenoid metabolism. The genes are grouped according to their functions: ggs1, carRA, carB, carT, and carD involved in NX biosynthesis and carX and carO involved in retinal and CarO rhodopsin production. Orange colors correspond to the genes organized as a cluster, and blue color to genes unlinked in the genome. Darker colors indicate cultures incubated in the dark and paler colors indicate cultures illuminated for one hour. (A) Above: wild-type strain IMI58289 of F. fujikuroi and its carS mutant SG39. Below: wild type strain 4287 of F. oxysporum (f. sp. lycopersici) and its carS mutant SX2; (B) Effect of light on the mRNA levels of the carS mutant SG39. RNA-seq data and culture conditions correspond to analyses already described [71]. In brief, all strains were cultured for three days in dark in minimal medium (DG medium for F. fujikuroi and DG with 3 g asparagine instead of NaNO3 for F. oxysporum). In the cases indicated, the cultures were exposed to one hour of illumination. RNA samples were sequenced with Illumina technology and the resulting data were analyzed with software tools for read mapping (Bowtie and TopHat), transcriptome assembly (Cuffmerge and Cufflinks), and differential gene expression analysis (Cuffdiff and CummeRbund).
The study of the transcriptional photoinduction of the structural genes for carotenogenesis in the mutants of the wcoA and cryD genes is consistent with different mechanisms of action for the encoded photoreceptors [65]. After illumination, the wcoA mutants exhibit photoinduction of carotenogenesis, but they accumulate carotenoids more slowly and their total levels do not reach those of the wild type. However, both the carotenoid content and the mRNA levels for the structural car genes are much lower in the dark in the wcoA mutants than in the wild type. Even more, the transcriptional photoinduction of the car genes is basically absent in the wcoA mutants, with mRNA levels after illumination lower than those of the wild type in the dark. Therefore, the induction of carotenogenesis by the alternative photoreceptor, presumably CryD, must be done through a transcription-independent mechanism. The molecular basis for such a mechanism, that could involve mRNA stability or translation and enzymatic activities or stabilities, remains to be elucidated.
The decay of the mRNA levels after photoinduction has been investigated in detail in N. crassa. In this fungus, the small flavin prohotoreceptor VIVID (VVD), its name due to the higher carotenoid levels of the vvd mutants under light, plays a key role in deactivating the WC photoreceptor system after illumination [70]. In contrast, the mutation of the VIVID ortholog in F. fujikuroi, called vvdA, results in a lower carotenoid accumulation in this fungus [72]. The kinetics of carotenogenesis in the vvdA mutants show a faster carotenoid accumulation immediately after light exposure, consistent with an attenuating function of VvdA on the photoactivated WcoA, but a slower accumulation after more prolonged growth under light, suggesting an up-regulating role during the second stage of carotenoid photoinduction [65].
5. Down-Regulation of Carotenoid Production: The CarS Gene
Standard mutagenesis protocols allow the identification of Fusarium mutants affected in the synthesis of carotenoids, easy to detect because of their changes in pigmentation. Such mutants are more easily identified on minimal medium, such as the DG minimal agar [73], than on richer media, e.g., Potato Dextrose Agar (PDA), which frequently results in the accumulation of other unrelated pigments which may mask the color of carotenoids. Carotenoid mutants usually identified by visual inspection are either albino in the light, as those lacking an early enzymatic step of the carotenoid pathway, or deeply pigmented in the dark, affected in a down-regulating function. The deep-orange mutants, exhibiting a light-independent carotenoid production and generically called carS, have been described in F. fujikuroi [22] and F. oxysporum [68]. The carS mutants have been investigated in detail in F. fujikuroi, where they accumulate an increasing amount of carotenoids with aging [55] and contain large amounts of mRNA for the structural genes, from carRA to carD [38,42,48,59] (Figure 3). This up-regulation results in an increase of carotenogenic enzymes, as deduced from the study of in vitro carotenogenesis in a cell-free system of a carS mutant compared to the wild type [74]. Because of their high carotenoid content, the effect of light is less apparent in the carS mutants, but expression studies have found a detectable photoinduction of the transcript levels for the structural genes. This has been found in F. fujikuroi [42] and in F. oxysporum [68], and it has been recently corroborated in F. fujikuroi in RNA-seq analyses (Figure 3).
The qualitative mixture of carotenoids accumulated by two carS mutants of F. fujikuroi obtained in different genetic backgrounds is similar to that of their corresponding wild types under light, with minor differences, mainly a lower torulene content in the carS strains (Figure 4). Because of the large accumulation of carotenoids in the dark, these mutants are also useful to investigate possible damaging effects of light on the carotenoids. The comparison of the chromatograms from dark or light-grown cultures in two carS mutants reveal again only minor changes, with a decrease in torulene and an increase in β-carotene in the samples from the illuminated cultures (Figure 4), which could be due to different sensitivities of these carotenes to light. Because of their intense pigmentation, the carS mutants have been useful tools to detect mutants with qualitative alterations in the carotenoid mixtures, e.g., making possible the identification of torulene accumulating mutants [22] or mutants with alterations in substrate recognition by the CarB desaturase [30]. The carS mutants have been also an optimal background to check the effect of possible carotenoid inhibitors on Fusarium carotenogenesis, revealing the differential efficiency of some cyclase inhibitors that were fully active in other species [55].
Figure 4.
HPLC analysis of carotenoids produced by two different wild types of F. fujikuroi and the carS mutants SG39 [22] and SF116 [48]. The strains were grown for 7 days on DG minimal medium in the dark or under light (7 W m−2 white light). The method for HPLC separation has been described [75]. In brief, the samples were run in a reverse-phase C18 column with a binary-gradient elution (acetone : deionized water) at a flow rate of 1 mL/min. Detection was performed at 450 nm and online UV/Visible absorption spectra were acquired in the wavelength range 350–600 nm. The UV/Visible spectra of the identified carotenoids are shown above. The peak X corresponds to an unknown carotenoid with maximal absorbance at 480 nm, whose identity is under investigation. The peak 1’ is assigned as a neurosporaxanthin isomer. Phytofluene cannot be detected at 450 nm, but traces of this carotene were detected at 368 nm (data not shown). The inner picture shows the pigmentation of 7-day old colonies of the wild strain IMI58289 and the carS mutant SG39 grown on minimal DG medium in the dark.
The gene carS was found to code for a protein of the RING finger (RF) family. The assignation was based in the identification of relevant mutations in all the carS mutants analyzed so far, the deep-pigmented phenotype resulting from the targeted mutation of the gene in F. oxysporum [68] and the complementation of the carS mutation in F. fujikuroi [76]. The predicted CarS protein has sequence similarity with the protein CrgA of M. circinelloides, whose mutation results in a similar carotenoid overproducing pattern in this species [77,78]. The degree of similarity between the CarS and CrgA proteins is not very high, as expected for two taxonomically distant fungi, but it covers the most relevant CrgA domains. These include two amino-terminal RF domains, one of them initially disregarded in CarS because of a wrong intron assignation in the F. fujikuroi genome annotation [71], and a LON protease domain [79]. However, CrgA has two glutamine-rich regions and a carboxy-terminal isoprenylation site, the first one underrepresented and the second absent in CarS. In other proteins, the RF domains interact with E3 ligase-type enzymes that mediate ubiquitylation of target proteins, frequently as a label for their degradation. The function of CrgA of M. circinelloides has received considerable attention, and the available information may provide some clues on the hypothetical way of action of CarS in Fusarium. At least one of the RF domains of CrgA is essential for its regulatory function in carotenogenesis, suggesting that this protein might function as an E3 ubiquitin ligase [78]. However, CrgA interacts with one of the three WC proteins of M. circinelloides, MCWC-1b, to trigger its degradation through an ubiquitylation-independent mechanism [80]. There are other similarities between CarS and CrgA functions. First, as found for the carS mutants in Fusarium, carotenoid biosynthesis maintains a detectable photoinduction in the crgA mutants of M. circinelloides [77]. Second, both CrgA and CarS are involved in other processes in addition to carotenogenesis, pointing to wider regulatory functions. This is supported by the alterations in growth and sporulation by the crgA mutants of M. circinelloides [81,82], and in gibberellin and bikaverin productions by the carS mutants of F. fujikuroi [83,84].
Interestingly, carS mutants have not been described in other Fusarium species and they could not be found in mutagenesis screenings in F. verticillioides (J. García-Martínez and V. Díaz-Sánchez, unpublished observations). However, the carS gene of F. fujikuroi is able to restore a basal carotenoid production upon introduction in a carS mutant of F. oxysporum, although not totally at the level of expression of the structural genes, indicating a functional conservation in both species [68].
6. Regulation by Light-Independent Factors
Nitrogen availability controls the production of different Fusarium secondary metabolites. Well-known examples are the productions of gibberellins, bikaverin, and fusarubin, induced by the absence of nitrogen through a complex regulatory network [85]. However, other metabolites, as fusarins and fusaric acid, exhibit an opposite regulatory pattern, with a higher production under excess of nitrogen [86]. Experiments with immobilized mycelia of F. fujikuroi incubated under low nitrogen conditions, to which excess nitrogen was subsequently added, revealed a higher synthesis of carotenoids under nitrogen starvation [87]. The negative effect of nitrogen was confirmed with the exchange of media between immobilized mycelia samples with different nitrogen contents, resulting in enhanced or reduced synthesis depending on the pass to low or high nitrogen conditions, respectively, indicating that the repressing effect is reversible.
In a different approach, the effect of nitrogen was studied in shake cultures of wild type and carS mutants. The production of carotenoids was higher in low nitrogen medium (low N/C ratio) than in high nitrogen medium (high N/C) in either of the tested strains [84]. A different set of experiments, in which cultures grown under an excess of nitrogen were transferred to a nitrogen-free solution, showed an increase of transcript levels of the structural genes carRA and carB after the transfer, which was accompanied by an enhanced accumulation of carotenoids. As found for photoinduction (see Section 3), the transcriptional increase was transitory, with maximal levels found in this case after more than 10 h following nitrogen deprivation.
The stimulatory effect of nitrogen starvation on F. fujikuroi carotenogenesis, either at mRNA or carotenoid levels, is additive with the one produced by light [84], indicating different activating mechanisms. The regulation of carotenogenesis by nitrogen has been also described in N. crassa, where the mRNA levels for the carRA and carB orthologs al-1 and al-2 increase considerably under nitrogen limitation compared to standard nitrogen conditions, either in the wild type or in blind wc mutants [88]. The regulation by nitrogen might involve control of expression at the level of chromatin structure, as indicated by the differences in histone methylation found for the genes of the car cluster in a mutant of the methyltransferase KMT6 in Fusarium graminearum [89]. In F. fujikuroi, the expression of several nitrogen-regulated clusters for secondary metabolite production correlate with H3K9 acetylation [90]. This suggests a similar mechanism in the regulation of the structural car genes, which is currently under investigation.
Other regulatory circuits may also influence the control of carotenoid biosynthesis. A major regulatory pathway is the one involving cAMP, produced by adenylate cyclase under the stimulation of a Gα unit from a heterotrimeric G protein. cAMP acts on other proteins, including protein kinases that phosphorylate target proteins to module their activity. The mutation of the adenylate cyclase gene acyA in F. fujikuroi results in higher levels of carotenoids in the dark but in a reduced photoinduction [91]. The mutation affects other phenotypes, as the growth pattern or the production of other secondary metabolites. Another study in the same species, that extended the analysis to the effect of mutations of two adenylyl cyclase-stimulating Gα subunits and two cAMP-dependent PKs, confirmed different alterations in secondary metabolism and development [92], but in this case the effect on carotenogenesis was not investigated. Carotenogenesis may also have a regulatory connection with sexual development, as suggested by the lower carotenoid photoinduction of the mutants of the MAT1-2-1 mating-type gene of F. verticillioides [69].
In N. crassa, besides the regulation by light, the synthesis of carotenoids is coupled to conidiation in a light-independent manner [70]. Actually, conidiation is stimulated by light and aerial growth in this fungus, leading to a massive conidia production that provides a typical orange pigmentation in slant cultures. Conidiation is less abundant in Fusarium, and the synthesis of carotenoids in the conidia has been usually disregarded. A comparison of the effect of light on the amount of carotenoids in mycelia and conidia from surface cultures in a wild type and a carS mutant of F. oxysporum showed the conservation in the conidia of the regulation by light and the deregulation by the carS mutation [93] (Figure 5). The low amount of carotenoids in wild type conidia in the dark indicates the lack of a developmental induction as the one described in N. crassa.
Figure 5.
Conidiation and carotenoid biosynthesis in F. oxysporum. (A) Aspect of colonies of the wild type strain 4287 of F. oxysporum (f. sp. lycopersici) and its carS mutant SX2 grown on DG minimal medium at 30 °C for 7 days in the dark or under 5 w m−2 white light. Pictures on the right show the aspect of precipitated conidia obtained from the colonies as described [59]; (B) total amounts of conidia per Petri dish produced by the same strains under the indicated culture conditions; (C) total amounts of carotenoids accumulated in the mycelia and in the conidia mentioned above. The strains were grown in the dark (left darker bars) or under light (right paler bars). Data adapted from [93].
The cellular location of carotenoid biosynthesis is a regulatory aspect that has received little attention. Because of their hydrophobic nature, the carotenoids are assumed to interact with membranes, but their subcellular distribution in Fusarium is unknown. A biochemical approach based on the specific labeling of different terpenoids from 14C-labeled mevalonate allowed to establish that the carotenoids are produced in different cell compartments than those where the gibberellins and the sterols are synthesized [94]. Experiments to visualize the physical location of the enzymes for carotenoid biosynthesis in the fungal cells, based in their fusion to fluorescent proteins, are currently underway.
7. Conclusions and Future Prospects
Following the early studies in F. aquaeductuum, the fungus F. fujikuroi, and more recently also F. oxysporum, have become reference models in the research of fungal carotenogenesis and a wealth of information has been accumulated on the biochemistry and genetics of their NX production. All the genes and enzymes of the biosynthetic pathway are known and current research work is dedicated to elucidate the molecular mechanisms of the regulation. The available information on the control by light has revealed an unexpected complexity in relation to the model system N. crassa, in which the White Collar complex is the only transcriptional activator of the structural genes for neurosporaxanthin biosynthesis. At least a second photoreceptor, the DASH cryptochrome CryD, is also involved in the photoresponse in Fusarium. Our current research efforts are centered in a better understanding of the regulation by light and by the CarS protein, and their possible connections. Studies on the mechanism of action of CarS are focused in the alteration of its expression and in the identification of interacting proteins. Efforts are also centered in the identification of regulatory proteins able to bind the promoters of the structural car genes, which might include CarS targets. The regulation may include epigenetic mechanisms, as those related with chromatin structure, also under study. While the biochemistry of the carotenoid pathway has many similarities between different producing fungi, the regulatory mechanisms have been the object of a higher diversification, allowing refined adaptations to respond more efficiently to the different needs in their respective natural habitats. The studies on the regulatory processes governing carotenoid biosynthesis in Fusarium are a promising area of research, which predictably may lead to the discovery of novel molecular mechanisms.
Acknowledgments
We thank the Spanish Government (projects BIO2012-39716, BIO2015-69613-R, AGL2014-53195R and CaRed Network BIO2015-71703-REDT) and Junta de Andalucía (project CTS-6638) for financial support.
Conflicts of Interest
The authors declare no conflict of interest.
References
- Booth, C. The Genus Fusarium; Commonwealth Agricultural Bureaux for the Commonwealth Mycological Institute: Farnham Royal, UK, 1971. [Google Scholar]
- Leslie, J.F.; Summerell, B.A. The Fusarium Laboratory Manual; Blackwell Professional: Ames, IA, USA, 2006. [Google Scholar]
- Carlile, M.J. A study of the factors influencing non-genetic variation in a strain of Fusarium oxysporum. J. Gen. Microbiol. 1956, 14, 643–654. [Google Scholar] [CrossRef] [PubMed]
- Britton, G.; Liaaen-Jensen, S.; Pfander, H. Carotenoids; Birkhäuser Verlag: Basel, Switzerland, 1998; Volumes 1 and 2. [Google Scholar]
- Britton, G.; Liaaen-Jensen, S.; Pfander, H. Carotenoids: Handbook; Birkhauser Verlag: Basel, Switzerland, 2004. [Google Scholar]
- Sandmann, G.; Misawa, N. Fungal carotenoids. In The Mycota X. Industrial Applications; Osiewacz, H.D., Ed.; Springer: Berlin, Germany, 2002; pp. 247–262. [Google Scholar]
- Avalos, J.; Díaz-Sánchez, V.; García-Martínez, J.; Castrillo, M.; Ruger-Herreros, M.; Limón, M.C. Carotenoids. In Biosynthesis and Molecular Genetics of Fungal Secondary Metabolites; Martín, J.F., García-Estrada, C., Zeilinger, S., Eds.; Springer: New York, NY, USA, 2014; pp. 149–185. [Google Scholar]
- Phadwal, K. Carotenoid biosynthetic pathway: Molecular phylogenies and evolutionary behavior of crt genes in eubacteria. Gene 2005, 345, 35–43. [Google Scholar] [CrossRef] [PubMed]
- Boronat, A.; Rodríguez-Concepción, M. Terpenoid biosynthesis in prokaryotes. Adv. Biochem. Eng. Biotechnol. 2015, 148, 3–18. [Google Scholar] [PubMed]
- Mandrioli, M.; Rivi, V.; Nardelli, A.; Manicardi, G.C. Genomic and cytogenetic localization of the carotenoid genes in the aphid genome. Cytogenet. Genome Res. 2016, 149, 207–217. [Google Scholar] [CrossRef] [PubMed]
- Domonkos, I.; Kis, M.; Gombos, Z.; Ughy, B. Carotenoids, versatile components of oxygenic photosynthesis. Prog. Lipid Res. 2013, 52, 539–561. [Google Scholar] [CrossRef] [PubMed]
- Blomhoff, R.; Blomhoff, H.K. Overview of retinoid metabolism and function. J. Neurobiol. 2006, 66, 606–630. [Google Scholar] [CrossRef] [PubMed]
- Avalos, J.; Limón, M.C. Biological roles of fungal carotenoids. Curr. Genet. 2015, 61, 309–324. [Google Scholar] [CrossRef] [PubMed]
- Rohdich, F.; Kis, K.; Bacher, A.; Eisenreich, W. The non-mevalonate pathway of isoprenoids: Genes, enzymes and intermediates. Curr. Opin. Chem. Biol. 2001, 5, 535–540. [Google Scholar] [CrossRef]
- Rau, W.; Zehender, C. Die Carotinoide von Fusarium aquaeductuum Lagh. Arch. Mikrobiol. 1959, 32, 423–428. [Google Scholar] [CrossRef] [PubMed]
- Zalokar, M. Isolation of an acidic pigment in Neurospora. Arch. Biochem. Biophys. 1957, 70, 568–571. [Google Scholar] [CrossRef]
- Aasen, A.J.; Jensen, S.L. Fungal carotenoids II. The structure of the carotenoid acid neurosporaxanthin. Acta Chem. Scand. 1965, 19, 1843–1853. [Google Scholar] [CrossRef] [PubMed]
- Valadon, L.R.G.; Mummery, R.S. Biosynthesis of neurosporaxanthin. Microbios 1969, 1A, 3–8. [Google Scholar]
- Valadon, L.R.G.; Osman, M.; Mummery, R.S.; Jerebzoff-Quintin, S.; Jerebzoff, S. The effect of monochromatic radiation in the range 350 to 750 nm on the carotenogenesis in Verticillium agaricinum. Physiol. Plant. 1982, 56, 199–203. [Google Scholar] [CrossRef]
- Strobel, I.; Breitenbach, J.; Scheckhuber, C.Q.; Osiewacz, H.D.; Sandmann, G. Carotenoids and carotenogenic genes in Podospora anserina: Engineering of the carotenoid composition extends the life span of the mycelium. Curr. Genet. 2009, 55, 175–184. [Google Scholar] [CrossRef] [PubMed]
- Bindl, E.; Lang, W.; Rau, W. Untersuchungen über die lichtabhängige Carotinoidsynthese. VI. Zeitlicher Verlauf der Synthese der einzelnen Carotinoide bei Fusarium aquaeductuum unter verschiedenen Induktionsbedingungen. Planta 1970, 94, 156–174. [Google Scholar] [CrossRef] [PubMed]
- Avalos, J.; Cerdá-Olmedo, E. Carotenoid mutants of Gibberella fujikuroi. Curr. Genet. 1987, 25, 1837–1841. [Google Scholar] [CrossRef]
- Sakaki, H.; Kaneno, H.; Sumiya, Y.; Tsushima, M.; Miki, W.; Kishimoto, N.; Fujita, T.; Matsumoto, S.; Komemushi, S.; Sawabe, A. A new carotenoid glycosyl ester isolated from a marine microorganism, Fusarium strain T-1. J. Nat. Prod. 2002, 65, 1683–1684. [Google Scholar] [CrossRef] [PubMed]
- Woitek, S.; Unkles, S.E.; Kinghorn, J.R.; Tudzynski, B. 3-Hydroxy-3-methylglutaryl-CoA reductase gene of Gibberella fujikuroi: Isolation and characterization. Curr. Genet. 1997, 31, 38–47. [Google Scholar] [CrossRef] [PubMed]
- Homann, V.; Mende, K.; Arntz, C.; Ilardi, V.; Macino, G.; Morelli, G.; Bose, G.; Tudzynski, B. The isoprenoid pathway: Cloning and characterization of fungal FPPS genes. Curr. Genet. 1996, 30, 232–239. [Google Scholar] [CrossRef] [PubMed]
- Mende, K.; Homann, V.; Tudzynski, B. The geranylgeranyl diphosphate synthase gene of Gibberella fujikuroi: Isolation and expression. Mol. Gen. Genet. 1997, 255, 96–105. [Google Scholar] [CrossRef] [PubMed]
- Tudzynski, B. Gibberellin biosynthesis in fungi: Genes, enzymes, evolution, and impact on biotechnology. Appl. Microbiol. Biotechnol. 2005, 66, 597–611. [Google Scholar] [CrossRef] [PubMed]
- Fernández-Martín, R.; Cerdá-Olmedo, E.; Avalos, J. Homologous recombination and allele replacement in transformants of Fusarium fujikuroi. Mol. Gen. Genet. 2000, 263, 838–845. [Google Scholar] [CrossRef] [PubMed]
- Schmidhauser, T.J.; Lauter, F.R.; Russo, V.E.; Yanofsky, C. Cloning, sequence, and photoregulation of al-1, a carotenoid biosynthetic gene of Neurospora crassa. Mol. Cell. Biol. 1990, 10, 5064–5070. [Google Scholar] [CrossRef] [PubMed]
- Prado-Cabrero, A.; Schaub, P.; Díaz-Sánchez, V.; Estrada, A.F.; Al-Babili, S.; Avalos, J. Deviation of the neurosporaxanthin pathway towards β-carotene biosynthesis in Fusarium fujikuroi by a point mutation in the phytoene desaturase gene. FEBS J. 2009, 276, 4582–4597. [Google Scholar] [CrossRef] [PubMed]
- Hausmann, A.; Sandmann, G. A single five-step desaturase is involved in the carotenoid biosynthesis pathway to β-carotene and torulene in Neurospora crassa. Fungal Genet. Biol. 2000, 30, 147–153. [Google Scholar] [CrossRef] [PubMed]
- Schmidhauser, T.J.; Lauter, F.R.; Schumacher, M.; Zhou, W.; Russo, V.E.; Yanofsky, C. Characterization of al-2, the phytoene synthase gene of Neurospora crassa. Cloning, sequence analysis, and photoregulation. J. Biol. Chem. 1994, 269, 12060–12066. [Google Scholar] [PubMed]
- Linnemannstöns, P.; Prado, M.M.; Fernández-Martín, R.; Tudzynski, B.; Avalos, J. A carotenoid biosynthesis gene cluster in Fusarium fujikuroi: the genes carB and carRA. Mol. Genet. Genomics 2002, 267, 593–602. [Google Scholar] [CrossRef] [PubMed]
- Verdoes, J.C.; Krubasik, P.; Sandmann, G.; van Ooyen, A.J.J. Isolation and functional characterisation of a novel type of carotenoid biosynthetic gene from Xanthophyllomyces dendrorhous. Mol. Gen. Genet. 1999, 262, 453–461. [Google Scholar] [CrossRef] [PubMed]
- Arrach, N.; Schmidhauser, T.J.; Avalos, J. Mutants of the carotene cyclase domain of al-2 from Neurospora crassa. Mol. Genet. Genom. 2002, 266, 914–921. [Google Scholar]
- Díaz-Sánchez, V.; Estrada, A.F.; Trautmann, D.; Limón, M.C.; Al-Babili, S.; Avalos, J. Analysis of al-2 mutations in Neurospora. PLoS ONE 2011, 6, e21948. [Google Scholar] [CrossRef] [PubMed]
- Sui, X.; Kiser, P.D.; von Lintig, J.; Palczewski, K. Structural basis of carotenoid cleavage: From bacteria to mammals. Arch. Biochem. Biophys. 2013, 539, 203–213. [Google Scholar] [CrossRef] [PubMed]
- Thewes, S.; Prado-Cabrero, A.; Prado, M.M.; Tudzynski, B.; Avalos, J. Characterization of a gene in the car cluster of Fusarium fujikuroi that codes for a protein of the carotenoid oxygenase family. Mol. Genet. Genom. 2005, 274, 217–228. [Google Scholar] [CrossRef] [PubMed]
- Prado-Cabrero, A.; Scherzinger, D.; Avalos, J.; Al-Babili, S. Retinal biosynthesis in fungi: Characterization of the carotenoid oxygenase CarX from Fusarium fujikuroi. Eukaryot. Cell 2007, 6, 650–657. [Google Scholar] [CrossRef] [PubMed]
- Estrada, A.F.; Avalos, J. Regulation and targeted mutation of opsA, coding for the NOP-1 opsin orthologue in Fusarium fujikuroi. J. Mol. Biol. 2009, 387, 59–73. [Google Scholar] [CrossRef] [PubMed]
- Díaz-Sánchez, V.; Limón, M.C.; Schaub, P.; Al-Babili, S.; Avalos, J. A RALDH-like enzyme involved in Fusarium verticillioides development. Fungal Genet. Biol. 2016, 86, 20–32. [Google Scholar] [CrossRef] [PubMed]
- Prado-Cabrero, A.; Estrada, A.F.; Al-Babili, S.; Avalos, J. Identification and biochemical characterization of a novel carotenoid oxygenase: Elucidation of the cleavage step in the Fusarium carotenoid pathway. Mol. Microbiol. 2007, 64, 448–460. [Google Scholar] [CrossRef] [PubMed]
- Saelices, L.; Youssar, L.; Holdermann, I.; Al-Babili, S.; Avalos, J. Identification of the gene responsible for torulene cleavage in the Neurospora carotenoid pathway. Mol. Genet. Genom. 2007, 278, 527–537. [Google Scholar] [CrossRef] [PubMed]
- Jin, J.M.; Lee, J.; Lee, Y.W. Characterization of carotenoid biosynthetic genes in the ascomycete Gibberella zeae. FEMS Microbiol. Lett. 2010, 302, 197–202. [Google Scholar] [CrossRef] [PubMed]
- Goldie, A.H.; Subden, R.E. The neutral carotenoids of wild-type and mutant strains of Neurospora crassa. Biochem. Genet. 1973, 10, 275–284. [Google Scholar] [CrossRef] [PubMed]
- Sandmann, G. Photoregulation of carotenoid biosynthesis in mutants of Neurospora crassa: Activities of enzymes involved in the synthesis and conversion of phytoene. Z. Naturforsch. 1993, 48c, 570–574. [Google Scholar]
- Estrada, A.F.; Youssar, L.; Scherzinger, D.; Al-Babili, S.; Avalos, J. The ylo-1 gene encodes an aldehyde dehydrogenase responsible for the last reaction in the Neurospora carotenoid pathway. Mol. Microbiol. 2008, 69, 1207–1220. [Google Scholar] [CrossRef] [PubMed]
- Díaz-Sánchez, V.; Estrada, A.F.; Trautmann, D.; Al-Babili, S.; Avalos, J. The gene carD encodes the aldehyde dehydrogenase responsible for neurosporaxanthin biosynthesis in Fusarium fujikuroi. FEBS J. 2011, 278, 3164–3176. [Google Scholar] [CrossRef] [PubMed]
- Rau, W. Über den Einfluss der Temperatur auf die lichtabhängige Carotinoidbildung von Fusarium aquaeductuum. Planta 1962, 59, 123–137. [Google Scholar] [CrossRef]
- Rau, W. Untersuchungen über die lichtabhängige Carotinoidsynthese. II. Ersatz der Lichtinduktion durch Mercuribenzoat. Planta 1967, 74, 263–277. [Google Scholar] [CrossRef] [PubMed]
- Rau, W. Untersuchungen über die lichtabhängige Carotinoidsynthese. VII. Reversible Unterbrechung der Reaktionskette durch Cycloheximid und anaerobe Bedingungen. Planta 1971, 101, 251–264. [Google Scholar] [CrossRef] [PubMed]
- Rau, W.; Feuser, B.; Rau-Hund, A. Substitution of p-chloro- or p-hydroxymercuribenzoate for light in carotenoid synthesis by Fusarium aquaeductuum. Biochim. Biophys. Acta 1967, 136, 589–590. [Google Scholar] [CrossRef]
- Theimer, R.R.; Rau, W. Untersuchungen über die lichtabhängige Carotinoidsynthese V. Aufhebung der Lichtinduktion dutch Reduktionsmittel und Ersatz des Lichts durch Wasserstoffperoxid. Planta 1970, 92, 129–137. [Google Scholar] [CrossRef] [PubMed]
- Theimer, R.R.; Rau, W. Untersuchungen über die lichtabhängige Carotinoidsynthese VIII. Die unterschiedlichen Wirkungsmechanismen von Licht und Mercuribenzoat. Planta 1972, 106, 331–343. [Google Scholar] [CrossRef] [PubMed]
- Avalos, J.; Cerdá-Olmedo, E. Chemical modification of carotenogenesis in Gibberella fujikuroi. Phytochemistry 1986, 25, 1837–1841. [Google Scholar] [CrossRef]
- Rau, W. Untersuchungen über die lichtabhängige Carotinoidsynthese. I. Das Wirkungsspektrum von Fusarium aquaeductuum. Planta 1967, 72, 14–28. [Google Scholar] [CrossRef] [PubMed]
- Schrott, E.L.; Huber-Willer, A.; Rau, W. Is phytochrome involved in the light-mediated carotenogenesis in Fusarium aquaeductuum and Neurospora crassa? Photochem. Photobiol. 1982, 35, 213–216. [Google Scholar] [CrossRef]
- Lang-Feulner, J.; Rau, W. Redox dyes as artificial photoreceptors in light-dependent carotenoid synthesis. Photochem. Photobiol. 1975, 21, 179–183. [Google Scholar] [CrossRef] [PubMed]
- Prado, M.M.; Prado-Cabrero, A.; Fernández-Martín, R.; Avalos, J. A gene of the opsin family in the carotenoid gene cluster of Fusarium fujikuroi. Curr. Genet. 2004, 46, 47–58. [Google Scholar] [CrossRef] [PubMed]
- De Fabo, E.C.; Harding, R.W.; Shropshire, W., Jr. Action spectrum between 260 and 800 nanometers for the photoinduction of carotenoid biosynthesis in Neurospora crassa. Plant Physiol. 1976, 57, 440–445. [Google Scholar] [CrossRef] [PubMed]
- Fischer, R.; Aguirre, J.; Herrera-Estrella, A.; Corrochano, L.M. The complexity of fungal vision. Microbiol. Spectr. 2016, 4, 1–22. [Google Scholar]
- Estrada, A.F.; Avalos, J. The White Collar protein WcoA of Fusarium fujikuroi is not essential for photocarotenogenesis, but is involved in the regulation of secondary metabolism and conidiation. Fungal Genet. Biol. 2008, 45, 705–718. [Google Scholar] [CrossRef] [PubMed]
- Ruiz-Roldán, M.C.; Garre, V.; Guarro, J.; Mariné, M.; Roncero, M.I. Role of the white collar 1 photoreceptor in carotenogenesis, UV resistance, hydrophobicity, and virulence of Fusarium oxysporum. Eukaryot. Cell 2008, 7, 1227–1230. [Google Scholar] [CrossRef] [PubMed]
- Kim, H.; Son, H.; Lee, Y.-W. Effects of light on secondary metabolism and fungal development of Fusarium graminearum. J. Appl. Microbiol. 2014, 116, 380–389. [Google Scholar] [CrossRef] [PubMed]
- Castrillo, M.; Avalos, J. The flavoproteins CryD and VvdA cooperate with the white collar protein WcoA in the control of photocarotenogenesis in Fusarium fujikuroi. PLoS ONE 2015, 10, e0119785. [Google Scholar] [CrossRef] [PubMed]
- Castrillo, M.; Bernhardt, A.; Avalos, J.; Batschauer, A.; Pokorny, R. Biochemical characterization of the DASH-type cryptochrome CryD from Fusarium fujikuroi. Photochem. Photobiol. 2015, 91, 1356–1367. [Google Scholar] [CrossRef] [PubMed]
- Castrillo, M.; García-Martínez, J.; Avalos, J. Light-dependent functions of the Fusarium fujikuroi CryD DASH cryptochrome in development and secondary metabolism. Appl. Environ. Microbiol. 2013, 79, 2777–2788. [Google Scholar] [CrossRef] [PubMed]
- Rodríguez-Ortiz, R.; Michielse, C.; Rep, M.; Limón, M.C.; Avalos, J. Genetic basis of carotenoid overproduction in Fusarium oxysporum. Fungal Genet. Biol. 2012, 49, 684–696. [Google Scholar] [CrossRef] [PubMed]
- Ádám, A.L.; García-Martínez, J.; Szücs, E.P.; Avalos, J.; Hornok, L. The MAT1–2-1 mating-type gene upregulates photo-inducible carotenoid biosynthesis in Fusarium verticillioides. FEMS Microbiol. Lett. 2011, 318, 76–83. [Google Scholar] [CrossRef] [PubMed]
- Avalos, J.; Corrochano, L.M. Carotenoid biosynthesis in Neurospora. In Neurospora: Genomics and Molecular Biology; Kasbekar, D.P., McCluskey, K., Eds.; Caister Academic Press: Norfolk, UK, 2013; pp. 227–241. [Google Scholar]
- Ruger-Herreros, M. Participación de la Proteína CarS en la Regulación de la Carotenogénesis y el Estrés en Fusarium fujikuroi. Ph.D. Thesis, Universidad de Sevilla, Seville, Spain, 2016. [Google Scholar]
- Castrillo, M.; Avalos, J. Light-mediated participation of the VIVID-like protein of Fusarium fujikuroi VvdA in pigmentation and development. Fungal Genet. Biol. 2014, 71, 9–20. [Google Scholar] [CrossRef] [PubMed]
- Avalos, J.; Casadesús, J.; Cerdá-Olmedo, E. Gibberella fujikuroi mutants obtained with UV radiation and N-methyl-N’-nitro-N-nitrosoguanidine. Appl. Environ. Microbiol. 1985, 49, 187–191. [Google Scholar] [PubMed]
- Avalos, J.; Mackenzie, A.; Nelki, D.S.; Bramley, P.M. Terpenoid biosynthesis in cell-extracts of wild type and mutant strains of Gibberella fujikuroi. Biochim. Biophys. Acta 1988, 966, 257–265. [Google Scholar] [CrossRef]
- Delgado-Pelayo, R.; Hornero-Méndez, D. Identification and quantitative analysis of carotenoids and their esters from sarsaparrilla (Smilax aspera L.) berries. J. Agric. Food Chem. 2012, 60, 8225–8232. [Google Scholar] [CrossRef] [PubMed]
- Rodríguez-Ortiz, R.; Limón, M.C.; Avalos, J. Functional analysis of the carS gene of Fusarium fujikuroi. Mol. Genet. Genom. 2013, 288, 157–173. [Google Scholar] [CrossRef] [PubMed]
- Navarro, E.; Lorca-Pascual, J.M.; Quiles-Rosillo, M.D.; Nicolás, F.E.; Garre, V.; Torres-Martínez, S.; Ruiz-Vázquez, R.M. A negative regulator of light-inducible carotenogenesis in Mucor circinelloides. Mol. Genet. Genom. 2001, 266, 463–470. [Google Scholar]
- Lorca-Pascual, J.M.; Murcia-Flores, L.; Garre, V.; Torres-Martínez, S.; Ruiz-Vázquez, R.M. The RING-finger domain of the fungal repressor crgA is essential for accurate light regulation of carotenogenesis. Mol. Microbiol. 2004, 52, 1463–1474. [Google Scholar] [CrossRef] [PubMed]
- Navarro, E.; Ruiz-Pérez, V.L.; Torres-Martínez, S. Overexpression of the crgA gene abolishes light requirement for carotenoid biosynthesis in Mucor circinelloides. Eur. J. Biochem. 2000, 267, 800–807. [Google Scholar] [CrossRef] [PubMed]
- Silva, F.; Navarro, E.; Peñaranda, A.; Murcia-Flores, L.; Torres-Martínez, S.; Garre, V. A RING-finger protein regulates carotenogenesis via proteolysis-independent ubiquitylation of a White Collar-1-like activator. Mol. Microbiol. 2008, 70, 1026–1036. [Google Scholar] [CrossRef] [PubMed]
- Quiles-Rosillo, M.D.; Torres-Martínez, S.; Garre, V. Ciga, a light-inducible gene involved in vegetative growth in Mucor circinelloides is regulated by the carotenogenic repressor crgA. Fungal Genet. Biol. 2003, 38, 122–132. [Google Scholar] [CrossRef]
- Murcia-Flores, L.; Lorca-Pascual, J.M.; Garre, V.; Torres-Martínez, S.; Ruiz-Vázquez, R.M. Non-AUG translation initiation of a fungal RING finger repressor involved in photocarotenogenesis. J. Biol. Chem. 2007, 282, 15394–15403. [Google Scholar] [CrossRef] [PubMed]
- Candau, R.; Avalos, J.; Cerdá-Olmedo, E. Gibberellins and carotenoids in the wild type and mutants of Gibberella fujikuroi. Appl. Environ. Microbiol. 1991, 57, 3378–3382. [Google Scholar] [PubMed]
- Rodríguez-Ortiz, R.; Limón, M.C.; Avalos, J. Regulation of carotenogenesis and secondary metabolism by nitrogen in wild-type Fusarium fujikuroi and carotenoid-overproducing mutants. Appl. Environ. Microbiol. 2009, 75, 405–413. [Google Scholar] [CrossRef] [PubMed]
- Studt, L.; Tudzynski, B. Gibberellins and the red pigments bikaverin and fusarubin. In Biosynthesis and Molecular Genetics of Fungal Secondary Metabolites; Martín, J.-F., García-Estrada, C., Zeilinger, S., Eds.; Springer: New York, NY, USA, 2014; pp. 209–238. ISBN 978-1-4939-1190-5. [Google Scholar]
- Niehaus, E.-M.; Díaz-Sánchez, V.; von Bargen, K.W.; Kleigrewe, K.; Humpf, H.-U.; Limón, M.C.; Tudzynski, B. Fusarins and Fusaric Acid in Fusaria. In Biosynthesis and Molecular Genetics of Fungal Secondary Metabolites; Martín, J.-F., García-Estrada, C., Zeilinger, S., Eds.; Springer: New York, NY, USA, 2014; pp. 239–262. ISBN 978-1-4939-1190-5. [Google Scholar]
- Garbayo, I.; Vílchez, C.; Nava-Saucedo, J.E.; Barbotin, J.N. Nitrogen, carbon and light-mediated regulation studies of carotenoid biosynthesis in immobilized mycelia of Gibberella fujikuroi. Enzyme Microb. Technol. 2003, 33, 629–634. [Google Scholar] [CrossRef]
- Sokolovsky, V.Y.; Lauter, F.R.; Müller-Röber, B.; Ricci, M.; Schmidhauser, T.J.; Russo, V.E.A. Nitrogen regulation of blue light-inducible genes in Neurospora crassa. J. Gen. Microbiol. 1992, 138, 2045–2049. [Google Scholar] [CrossRef]
- Connolly, L.R.; Smith, K.M.; Freitag, M. The Fusarium graminearum histone H3 K27 methyltransferase KMT6 regulates development and expression of secondary metabolite gene clusters. PLoS Genet. 2013, 9, e1003916. [Google Scholar] [CrossRef] [PubMed]
- Wiemann, P.; Sieber, C.M.; von Bargen, K.W.; Studt, L.; Niehaus, E.M.; Espino, J.J.; Huss, K.; Michielse, C.B.; Albermann, S.; Wagner, D.; et al. Deciphering the cryptic genome: Genome-wide analyses of the rice pathogen Fusarium fujikuroi reveal complex regulation of secondary metabolism and novel metabolites. PLoS Pathog. 2013, 9, e1003475. [Google Scholar] [CrossRef] [PubMed]
- García-Martínez, J.; Ádám, A.L.; Avalos, J. Adenylyl cyclase plays a regulatory role in development, stress resistance and secondary metabolism in Fusarium fujikuroi. PLoS ONE 2012, 7, e28849. [Google Scholar] [CrossRef] [PubMed]
- Studt, L.; Humpf, H.-U.; Tudzynski, B. Signaling governed by G proteins and cAMP is crucial for growth, secondary metabolism and sexual development in Fusarium fujikuroi. PLoS ONE 2013, 8, e58185. [Google Scholar] [CrossRef] [PubMed]
- Rodríguez-Ortiz, R. Análisis Genético y Molecular del Fenotipo CarS en Fusarium. Ph.D. Thesis, Universidad de Sevilla, Seville, Spain, 2012. [Google Scholar]
- Domenech, C.E.; Giordano, W.; Avalos, J.; Cerdá-Olmedo, E. Separate compartments for the production of sterols, carotenoids and gibberellins in Gibberella fujikuroi. Eur. J. Biochem. 1996, 239, 720–725. [Google Scholar] [CrossRef] [PubMed]
© 2017 by the authors. Licensee MDPI, Basel, Switzerland. This article is an open access article distributed under the terms and conditions of the Creative Commons Attribution (CC BY) license (http://creativecommons.org/licenses/by/4.0/).